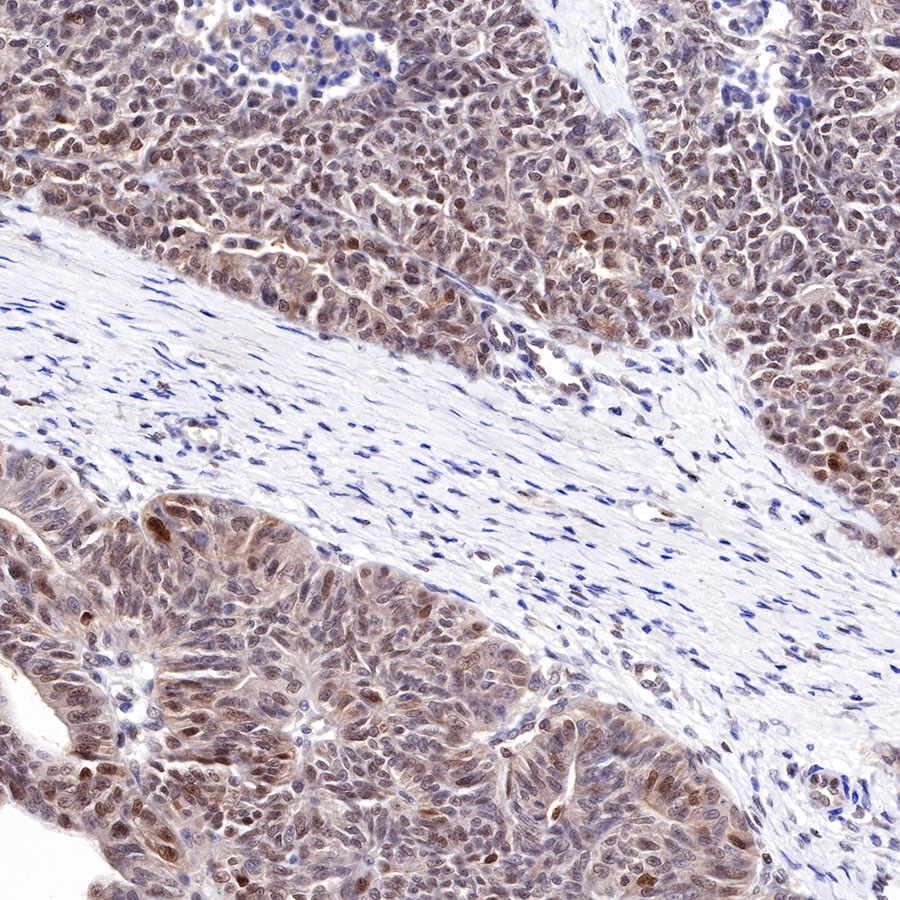

WB result of Cyclin D3 Rabbit mAb
Primary antibody: Cyclin D3 Rabbit mAb at 1/1000 dilution
Lane 1: HeLa whole cell lysate 20 µg
Lane 2: Jurkat whole cell lysate 20 µg
Lane 3: K562 whole cell lysate 20 µg
Secondary antibody: Goat Anti-Rabbit IgG, (H+L), HRP conjugated at 1/10000 dilution
Predicted MW: 33 kDa
Observed MW: 33 kDa
Product Details
Product Details
Product Specification
| Host | Rabbit |
| Antigen | Cyclin D3 |
| Synonyms | G1/S-specific cyclin-D3, CCND3 |
| Immunogen | N/A |
| Location | Cytoplasm, Nucleus |
| Accession | P30281 |
| Clone Number | SDT-R124 |
| Antibody Type | Rabbit mAb |
| Application | WB, IHC-P, ICC, ICFCM, IP |
| Reactivity | Hu |
| Purification | Protein A |
| Concentration | 0.5 mg/ml |
| Physical Appearance | Liquid |
| Storage Buffer | PBS, 40% Glycerol, 0.05% BSA, 0.03% Proclin 300 |
| Stability & Storage | 12 months from date of receipt / reconstitution, -20 °C as supplied |
Dilution
| application | dilution | species |
| IHC-P | 1:250-1:500 | null |
| WB | 1:1000 | null |
| IP | 1:50 | null |
| ICFCM | 1:500 | null |
| ICC | 1:500 | null |
Background
Transitions through the cell cycle are driven by cyclins and cyclin-dependent kinases (CDKs) [PubMed: 26658964]. Cyclins are the allosteric activators of cognate CDKs; their levels typically oscillate across the cell cycle, hence gaining the name cyclins. . The cyclin family shares a homologous N-terminal 100-amino acid motif referred as the cyclin box that has a highly conserved three-dimensional structure and provides the binding interface for the appropriate CDKs [PubMed: 8591034]. D cyclins, including cyclins D1, D2 and D3, form active complexes with either CDK4 or CDK6, which in turn phosphorylate the retinoblastoma protein (Rb) and drive G1 to S phase progression [PubMed: 7505440].
Picture
Picture
Western Blot

FC

Flow cytometric analysis of 4% PFA fixed 90% methanol permeabilized HeLa (Human cervix adenocarcinoma epithelial cell) cells labelling Cyclin D3 antibody at 1/500 dilution (0.1 μg)/ (Red) compared with a Rabbit monoclonal IgG (Black) isotype control and an unlabelled control (cells without incubation with primary antibody and secondary antibody) (Blue). Goat Anti - Rabbit IgG Alexa Fluor® 488 was used as the secondary antibody.
IP

Cyclin D3 Rabbit mAb at 1/50 dilution (1µg) immunoprecipitating Cyclin D3 in 0.4mg HeLa whole cell lysate.
Western blot was performed on the immunoprecipitate using Cyclin D3 Rabbit mAb at 1/1000 dilution.
Secondary antibody (HRP) for IP was used at 1/400 dilution.
Lane 1 : HeLa whole cell lysate 10µg(input)
Lane 2 : Cyclin D3 Rabbit mAb IP in HeLa whole cell lysate
Lane 3 : Rabbit monoclonal IgG IP in HeLa whole cell lysate
Predicted MW: 33 kDa
Observed MW: 33 kDa
Immunohistochemistry

IHC shows positive staining in paraffin-embedded human pancreas. Anti-Cyclin D3 antibody was used at 1/500 dilution, followed by a HRP Polymer for Mouse & Rabbit IgG (ready to use). Counterstained with hematoxylin. Heat mediated antigen retrieval with Tris/EDTA buffer pH9.0 was performed before commencing with IHC staining protocol.

IHC shows positive staining in paraffin-embedded human kidney. Anti-Cyclin D3 antibody was used at 1/250 dilution, followed by a HRP Polymer for Mouse & Rabbit IgG (ready to use). Counterstained with hematoxylin. Heat mediated antigen retrieval with Tris/EDTA buffer pH9.0 was performed before commencing with IHC staining protocol.

IHC shows positive staining in paraffin-embedded human placenta. Anti-Cyclin D3 antibody was used at 1/500 dilution, followed by a HRP Polymer for Mouse & Rabbit IgG (ready to use). Counterstained with hematoxylin. Heat mediated antigen retrieval with Tris/EDTA buffer pH9.0 was performed before commencing with IHC staining protocol.

IHC shows positive staining in paraffin-embedded human thyroid cancer. Anti-Cyclin D3 antibody was used at 1/250 dilution, followed by a HRP Polymer for Mouse & Rabbit IgG (ready to use). Counterstained with hematoxylin. Heat mediated antigen retrieval with Tris/EDTA buffer pH9.0 was performed before commencing with IHC staining protocol.
IHC shows positive staining in paraffin-embedded human ovarian cancer. Anti-Cyclin D3 antibody was used at 1/250 dilution, followed by a HRP Polymer for Mouse & Rabbit IgG (ready to use). Counterstained with hematoxylin. Heat mediated antigen retrieval with Tris/EDTA buffer pH9.0 was performed before commencing with IHC staining protocol.
Immunocytochemistry

ICC shows positive staining in HeLa cells. Anti-Cyclin D3 antibody was used at 1/500 dilution (Green) and incubated overnight at 4°C. Goat polyclonal Antibody to Rabbit IgG - H&L (Alexa Fluor® 488) was used as secondary antibody at 1/1000 dilution. The cells were fixed with 4%PFA and permeabilized with 0.1% PBS-Triton X-100. Nuclei were counterstained with DAPI (Blue).Counterstain with tubulin (red).
